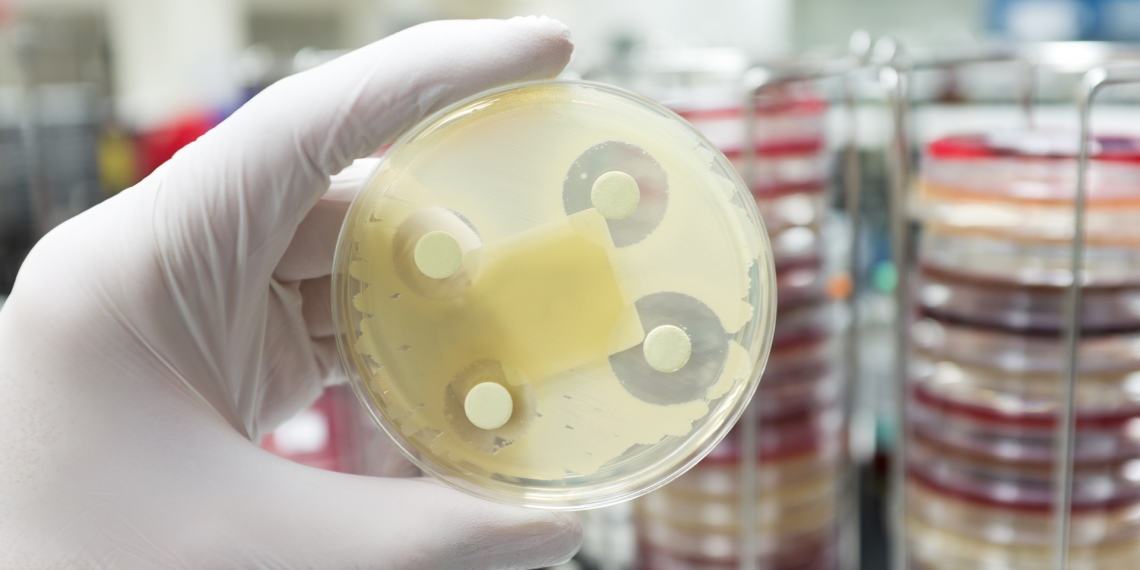
INESC TEC contribui para o desenvolvimento de protótipos capazes de melhorar o uso indevido de antibióticos

Antibiotics are widely recognised for treating infections caused by bacteria. However, one of the biggest global public health challenges is the well-documented misuse of these medicines, whether due to excessive and unnecessary prescriptions or the diagnostic inaccuracies that sometimes lead to their use.
In this sense, INESC TEC joined a new health-focused consortium called SMARTgNOSTICS – Global Testing & Diagnostics Solutions for Antimicrobial Resistances. The project aims to develop technologies that can minimise antibiotic use, enable faster and more accurate prescriptions, and help control the spread of antimicrobial resistance.
According to António Cardoso and Felipe Yamada, INESC TEC researchers in the field of industrial engineering and management, “the SMARTgNOSTICS project combines technology development with Artificial Intelligence (AI) in healthcare, aiming for the fast detection of bacteria and diseases, accelerating diagnosis, and facilitating treatment.” Moreover, and according to both, “the success of interdisciplinary collaboration between the various partners has allowed us to address the antimicrobial resistance problem comprehensively and develop an innovative AI-based solution. It shows how effective communication between different areas of study can converge into impactful solutions that promote human, animal, and environmental health.”
The solutions designed to detect and monitor bacterial infections and antimicrobial resistance are based on AI-powered Point-of-Care Testing (PoCT) devices. These small devices make it possible to carry out tests in loco, without relying on a traditional laboratory infrastructures. This means faster and more accurate diagnoses, as the data are collected and processed locally using AI.
SMARTgNOSTICS proposes this innovative approach under the holistic “One Health” concept, adapting solutions across four contexts: human health, animal health, the environment, and the agro-food sector.
The consortium brings together 11 partners with an investment of €21M. Launched in 2023, the project is now presenting the first prototypes at an event on October 3, in Viseu: Inovação no Controlo da Resistência Antimicrobiana – Biosensores, IA e Tecnologias Emergentes. This multidisciplinary meeting will bring together experts, researchers, and representatives from various fields to address the issue of antimicrobial resistance (AMR).
SMARTgNOSTICS is part of the Mobilising Agendas for Business Innovation, framed and funded under Portugal’s Recovery and Resilience Plan (PRR).
The researchers mentioned in this news piece are associated with INESC TEC.
News, current topics, curiosities and so much more about INESC TEC and its community!